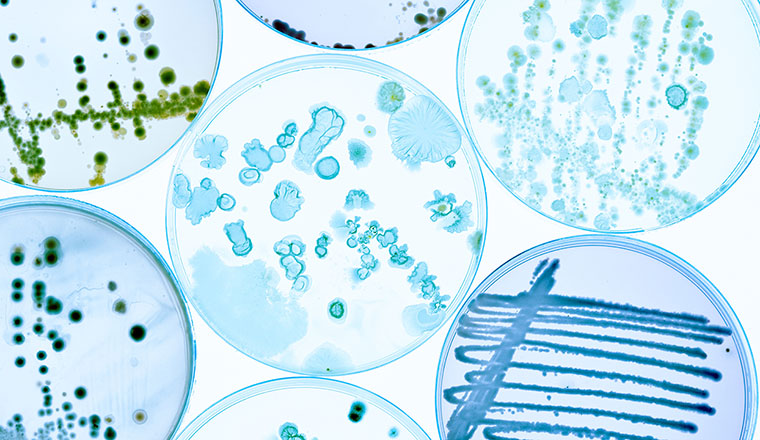

Allergènes
Réduisez les risques, assurez la conformité réglementaire, protégez votre marque et renforcez la confiance des consommateurs.
Nous proposons un large éventail de méthodes de détection pour tous les allergènes alimentaires pertinents. Nos services incluent des analyses fiables, des solutions analytiques précises et des conseils d’experts, ainsi qu’un étiquetage conforme aux exigences européennes.